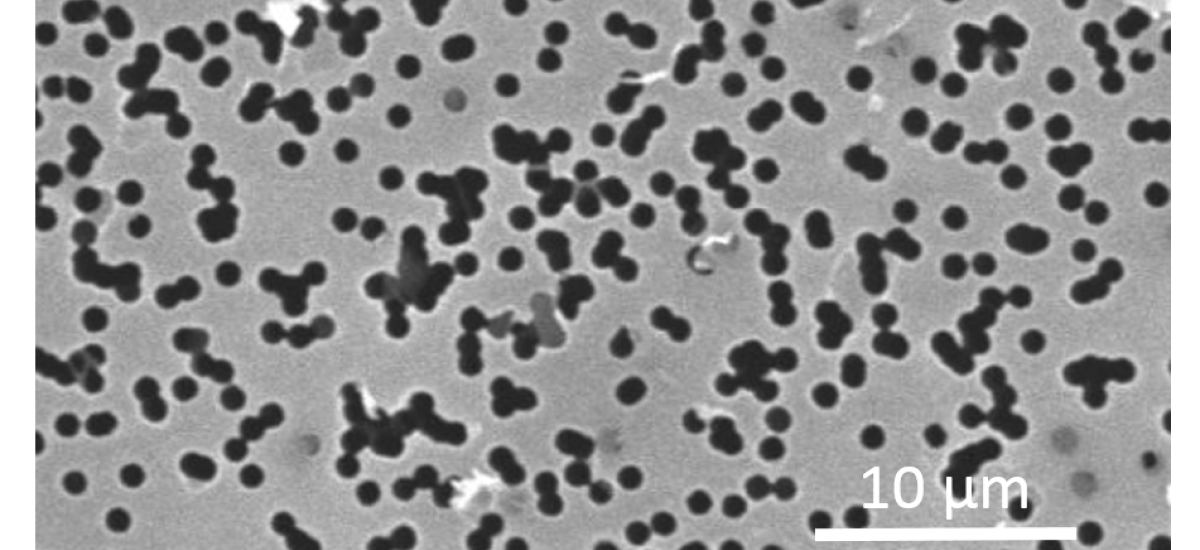

EBIS ion source
Mehr lesen
Fabrication of Nanoporous Graphene/Polymer Composite Membranes
Mehr lesen
Perforationg Freestanding Molybdenum Disulfide Monolayers with Highly Charged Ions
Mehr lesen
Creating nanoporous graphene with swift heavy ions
Mehr lesen
